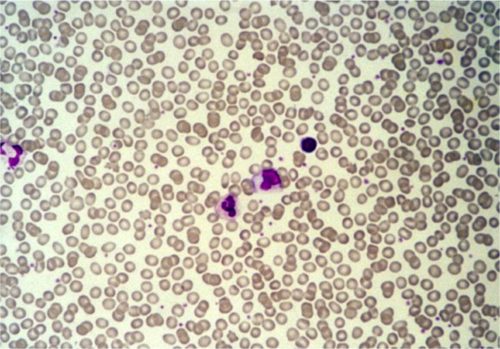

Что такое микроскоп

Современные микроскопы могут давать увеличение до 2000 крат, при котором качество изображения будет отличным.
Для исследования крови используют сложный микроскоп, так как он дает большое увеличение и обладает высокой разрешающей способностью. Действие основано на двухступенчатой схеме:
- Один объектив (линзу) подносят близко к объекту. Он увеличивает изображение с необходимым разрешением.
- Второй объектив (окуляр) располагают непосредственно близко к органу зрения наблюдателя.
Две системы линз располагаются на противоположных концах тубуса устройства. Штатив является основной частью тубуса.
Врачи отмечают, что под микроскопом кровь человека представляет собой сложную и удивительную структуру. Основными компонентами являются эритроциты, лейкоциты и тромбоциты. Эритроциты, имеющие характерную бочкообразную форму, отвечают за транспортировку кислорода, а их количество и состояние могут многое рассказать о здоровье пациента. Лейкоциты, в свою очередь, играют ключевую роль в иммунной защите организма, и их разнообразие позволяет врачам оценить наличие воспалительных процессов или инфекций. Тромбоциты, маленькие клеточные элементы, участвуют в процессе свертывания крови. Врачи подчеркивают, что анализ крови под микроскопом не только помогает диагностировать заболевания, но и служит важным инструментом для мониторинга состояния здоровья пациента.

Врачи отмечают, что под микроскопом кровь человека представляет собой сложную и динамичную систему. Эритроциты, или красные кровяные клетки, выглядят как бледные диски, которые обеспечивают транспорт кислорода. Их количество и форма могут варьироваться в зависимости от состояния здоровья пациента. Лейкоциты, белые кровяные клетки, заметно отличаются по размеру и форме, играя ключевую роль в иммунной защите организма. Врачи подчеркивают, что тромбоциты, отвечающие за свертываемость крови, выглядят как мелкие фрагменты, которые активно участвуют в заживлении повреждений. Исследование крови под микроскопом позволяет выявить множество заболеваний, включая анемию и инфекции, что делает этот метод незаменимым в клинической практике.
Как выглядит кровь под микроскопом
Существует несколько видов кровяных клеток, перед которыми поставлены различные задачи. Одни из них функционируют только внутри кровеносной системы, другие – выходят за ее пределы. Объединяет их только то, что все они образуются в костном мозге из стволовых клеток. Процесс их формирования непрерывен, а срок жизни ограничен. Лейкоциты, тромбоциты и эритроциты – 3 форменных элемента, содержащихся в биологической жидкости. Их количество зависит от возраста человека и состояния организма в данный момент.
Эритроциты

Каждую секунду погибает около 2-3 млн. данных телец, однако такое же их число каждую секунду и производится. Живут они приблизительно 4 месяца. В 1 куб. мл крови насчитывается около 25 млн. эритроцитов. Их общее число составляет 25 млрд. Всего лишь в одной капле крови наблюдается около 250 млн. эритроцитов.
Эритроцит под микроскопом дисковидно-вогнутой формы, диаметр которого в среднем составляет около 7-7,5 мкм, а толщина по краям – 2,5 мкм. Такая форма способствует “гладкому” прохождению красным кровяным тельцам по мелким сосудам. Со временем эритроциты утрачивают такое свойство, из-за чего задерживаются в мелких сосудах селезенки и печени. В этих органах они разрушаются.
До 80% эритроцитов имеют сферическую двояковогнутую форму. Остальные 20% могут быть овальной, серповидной, сферической (простой), чашеобразной и других форм. Изменение внешнего вида чаще обусловлено патологией (авитаминоз, анемия и т.п.).
При рассмотрении крови человека под микроскопом открывается удивительный мир. Люди часто описывают это зрелище как завораживающее и познавательное. Красные кровяные клетки, или эритроциты, выглядят как маленькие диски, которые плавно перемещаются по полю зрения, создавая впечатление бесконечного потока. Их яркий красный цвет свидетельствует о наличии гемоглобина, который отвечает за транспортировку кислорода.
Лейкоциты, или белые кровяные клетки, выделяются своей разнообразной формой и размерами. Они играют ключевую роль в иммунной системе, защищая организм от инфекций. Под микроскопом можно увидеть, как они активно движутся, что вызывает восхищение у наблюдателей.
Тромбоциты, отвечающие за свертывание крови, выглядят как мелкие фрагменты, которые собираются в группы при повреждении сосудов. Все эти элементы создают уникальную картину, которая отражает сложность и гармонию человеческого организма. Многие отмечают, что наблюдение за кровью под микроскопом помогает лучше понять важность здоровья и заботы о своем теле.
![КЛЕТКИ КРОВИ В ГЛАЗУ ЧЕЛОВЕКА! - [под микроскопом]](https://i.ytimg.com/vi/LFD0nbWS8dY/sddefault.jpg)
Под микроскопом кровь человека представляет собой удивительное зрелище. Люди, впервые увидевшие её под увеличением, часто поражаются разнообразием клеток и их формами. Красные кровяные клетки, или эритроциты, выглядят как маленькие диски, которые свободно плавают в плазме, придавая крови её характерный цвет. Белые кровяные клетки, отвечающие за иммунитет, имеют более сложную структуру и могут напоминать амёб, активно перемещающихся по “морю” крови. Тромбоциты, отвечающие за свертывание, выглядят как мелкие фрагменты, которые могут объединяться в группы. Многие отмечают, что наблюдение за кровью под микроскопом помогает лучше понять, как работает организм и как важна каждая клетка в поддержании здоровья. Это открытие вызывает восхищение и уважение к сложной системе, которая обеспечивает жизнь.
Лейкоциты
Это белые кровяные тельца, на которых возложена защитная функция. Их принято делить на гранулоциты и агранулоцит. К первой группе относятся зернистые клетки:
- Нейтрофилы. Самая многочисленная группа лейкоцитов – до 70% от общего числа белых клеток. Основная задача – захват болезнетворных микробов. Ядерная клетка имеет округлую форму, диаметр которой может достигать 10 мкм. Ядро может иметь вид палочки или состоять из нескольких сегментов, соединенных между собой. Если количество сегментов более 8, то это указывает на развитие заболевания.
- Базофилы. Немногочисленная группа, которая представлена не более 1% от всего количества лейкоцитов. Основная задача – поддержание работы иммунной системы. Имеют округлую форму и сегментированное или палочкообразное ядро. Их диаметр достигает 7-11 мкм.
- Эозинофилы. На общее число белых кровяных клеток приходится 2-5% эозинофилов. Их гранулы окрашиваются кислым красителем – эозином. У них округлая форма и слабо окрашенное ядро, состоящее из 2-3 сегментов одинаковой величины. В диаметре эозинофилы достигают 10-11 мкм. Их цитоплазма имеет бледно-голубой цвет.
В 1 куб. мл крови наблюдается 5-10 тыс. лейкоцитов. Средний размер белых кровяных телец равняется 15 мкм. Общее их число в человеческом организме достигает суммы в 35 млрд.
Вторая группа состоит из клеток без гранул в цитоплазме:
- Лимфоциты. Ведущий компонент иммунной системы. Зная, что такое лимфоциты в анализе крови, врачи определяют иммунный статус пациента и получают информацию о наличии в организме инфекции и других заболеваний. Это круглые клетки с большим ядром, занимающим большую часть цитоплазмы. Их диаметр составляет от 7 до 10 мкм. Ядро бывает круглым, овальным или бобовидным, имеет грубую структуру. Состоит их комков оксихроматина и базироматина, напоминающих глыбы.
- Моноциты. Самые крупные из лейкоцитов, отвечающие за неспецифическую защиту организма. Их количество от 2 до 9% от всех белых кровяных клеток. Диаметр доходит до 20 мкм. Ядро крупное, занимает почти всю цитоплазму, может быть круглым, бобовидным, иметь форму гриба, бабочки.
Интересно!Если расставить лейкоциты в один ряд, можно получить расстояние в 525 км.
Лейкограмма, или лейкоцитарная формула, – соотношение в процентах различных видов лейкоцитов, определяемое при подсчёте их в окрашенном мазке крови под микроскопом. Расшифровка лейкоцитарной формулы дает несомненную пользу при диагностическом поиске, однако не всегда может в полной мере удовлетворить интерес врача в отношении какой-то хорошо маскирующейся болезни. Например, чем более выражен воспалительный процесс бактериальной этиологии, тем больше нейтрофилов в лейкоцитарной формуле. Наличие нейтрофилов разной степени зрелости говорит о тяжести бактериальной инфекции. Чем острее процесс, тем больше в крови палочкоядерных нейтрофилов.
Тромбоциты

Что нельзя увидеть в микроскоп
В капле биологической жидкости под микроскопом нельзя увидеть:
- Глисты (яйца и их личинки). Теоретически некоторые виды гельминтов могут попасть в кровь и мигрировать с её током по организму. Однако здесь необходимо сопоставить размер клеток и яиц. Эритроцит в диаметре не более 10 мкм, яйцо шириной 50-85 мкм, высотой – 140-240. Личинки в диаметре еще крупнее. Но иногда эритроциты располагаются плоской стороной к наблюдателю. Именно эти странные палочки ошибочно принимают за глисты.
- Кристаллы. Существует мнение, что при обострении подагры соли мочевой кислоты можно обнаружить в крови. Однако увидеть такие кристаллы под микроскопом даже при 2000 увеличении нельзя. Кристаллы ошибочно могут принять за другие оставляющие биологической жидкости.
- Бактерии и простейшие. Чаще всего эксперименту подвергаются эритроциты. За счёт своей дискообразной формы с явным утоньшением в центре. Под определённым углом падения света они начинают выглядеть как яркий диск со светлым пятном посередине. Неопытный исследователь может подумать, что это и есть патогенный микроорганизм.
Иммунные клетки, свободные радикалы, токсины, грибки также нельзя распознать в крови под микроскопом.
Изучение биологической жидкости под микроскопом – одно из самых захватывающих направлений в микробиологии. Клетки крови имеют разную структуру и выполняют разные задачи. В первую очередь, для нормальной работы организма важен их количественный и качественный состав. Любые изменения могут указывать на развитие патологии. Поэтому первое, что сделает врач, направит пациента на сдачу анализа крови.
Вопрос-ответ
Что можно увидеть в образце крови под микроскопом?
Под микроскопом можно увидеть различные компоненты крови, такие как эритроциты (красные кровяные клетки), лейкоциты (белые кровяные клетки) и тромбоциты. Эритроциты имеют характерную двояковогнутую форму и отвечают за транспортировку кислорода. Лейкоциты представлены несколькими типами, каждый из которых выполняет свою функцию в иммунной системе. Тромбоциты, или кровяные пластинки, играют важную роль в процессе свертывания крови.
Какова роль лейкоцитов в организме человека?
Лейкоциты, или белые кровяные клетки, являются ключевыми элементами иммунной системы. Они защищают организм от инфекций и болезней, распознавая и уничтожая патогены, такие как бактерии и вирусы. Разные типы лейкоцитов выполняют специфические функции: некоторые активируют иммунный ответ, другие поглощают и уничтожают микробы, а третьи вырабатывают антитела для нейтрализации инфекций.
Почему важно изучать кровь под микроскопом?
Изучение крови под микроскопом позволяет врачам и исследователям диагностировать различные заболевания, такие как анемия, инфекции и нарушения свертываемости крови. Анализ клеточного состава крови помогает выявить отклонения от нормы, что может указывать на наличие заболеваний или состояний, требующих медицинского вмешательства. Кроме того, микроскопия крови используется для мониторинга эффективности лечения и общего состояния здоровья пациента.
Советы
СОВЕТ №1
Изучите основные компоненты крови, такие как эритроциты, лейкоциты и тромбоциты. Понимание их функций поможет вам лучше интерпретировать то, что вы видите под микроскопом.
СОВЕТ №2
Используйте качественные микроскопы с достаточным увеличением, чтобы увидеть детали клеток. Микроскопы с увеличением от 400x до 1000x идеально подходят для изучения крови.
СОВЕТ №3
Обратите внимание на подготовку образцов. Правильное окрашивание и подготовка слайдов могут значительно улучшить видимость клеток и их структур.
СОВЕТ №4
Сравните свои наблюдения с изображениями и видео, доступными в интернете. Это поможет вам лучше понять, как выглядят различные клетки крови и какие особенности стоит искать.